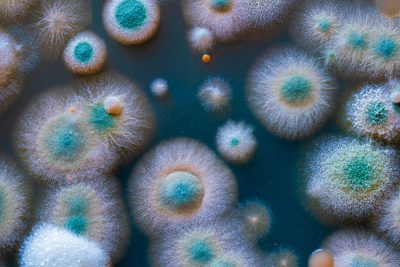
Mahwah NJ - Mold - A Health Concern

Mold Exposure Can Cause Health Problems
Mold in your home may make you or a member of your family sick. Exposure to mold can result in respiratory infections, bronchitis or asthma. Approximately 20% of America’s population has some form of mold allergy. Mold Testing NJ-NY is a certified mold inspection and testing service offering our experience and expertise to homeowners in Bergen County NJ and surrounding NJ and NY counties. Our focus is to find mold, test it and advise remediation when needed. Mold is a health concern and our goal is to keep your home free of toxic mold.
asthma. Approximately 20% of America’s population has some form of mold allergy. Mold Testing NJ-NY is a certified mold inspection and testing service offering our experience and expertise to homeowners in Bergen County NJ and surrounding NJ and NY counties. Our focus is to find mold, test it and advise remediation when needed. Mold is a health concern and our goal is to keep your home free of toxic mold.
What Are Symptoms Of Mold Allergy?
An allergic reaction to mold exposure can be itchy nose, eye irritation, coughing, or skin irritation. These can be worse due to immune deficiencies or lung disease. If you or a member of your household are wheezing, coughing, has chronic headaches, fatigue, or has come down with a mysterious illness, mold could be the cause. Doctors routinely check for mold allergies.
Mold Inspection And Testing By A Professional
Most mold is not visible and has no smell. The only sure way of knowing whether there is mold in your home is to test the air. Mold Testing NJ-NY is a certified mold inspection and testing service who can determine the presence of mold in your home. Often when we find that mold is present, we recommend remediation. It’s a good idea to be pro-active by protecting your health and the health of your family. Call Mold Testing NJ-NY for professional mold inspection and testing. We can be reached at (201) 658-8881.





